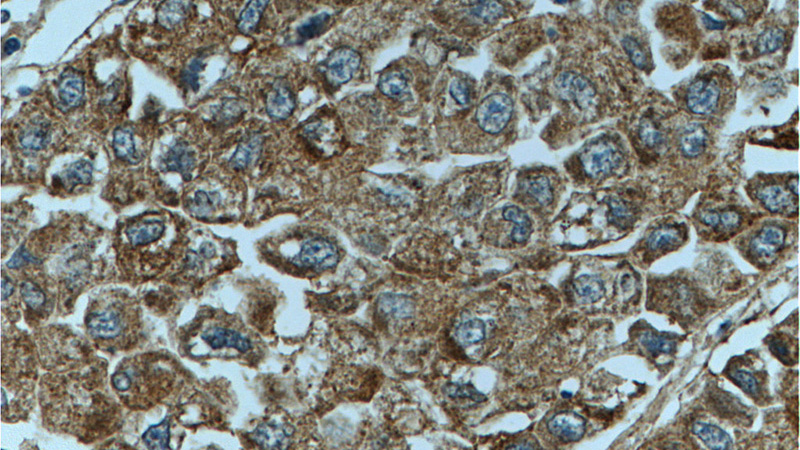
Immunohistochemistry of paraffin-embedded human liver cancer tissue slide using Catalog No:114059(PON2 Antibody) at dilution of 1:200 (under 40x lens)

-
Product Name
PON2 antibody
- Documents
-
Description
PON2 Rabbit Polyclonal antibody. Positive WB detected in human liver tissue, L02 cells. Positive IP detected in L02 cells. Positive IHC detected in human liver cancer tissue. Positive IF detected in HepG2 cells. Positive FC detected in HepG2 cells. Observed molecular weight by Western-blot: 39 kDa
-
Tested applications
ELISA, WB, IF, FC, IHC, IP
-
Species reactivity
Human; other species not tested.
-
Alternative names
A esterase 2 antibody; Aromatic esterase 2 antibody; paraoxonase 2 antibody; PON 2 antibody; PON2 antibody; Serum aryldialkylphosphatase 2 antibody
-
Isotype
Rabbit IgG
-
Preparation
This antibody was obtained by immunization of PON2 recombinant protein (Accession Number: BC046160). Purification method: Antigen affinity purified.
-
Clonality
Polyclonal
-
Formulation
PBS with 0.02% sodium azide and 50% glycerol pH 7.3.
-
Storage instructions
Store at -20℃. DO NOT ALIQUOT
-
Applications
Recommended Dilution:
WB: 1:200-1:2000
IP: 1:200-1:2000
IHC: 1:20-1:200
IF: 1:20-1:200
-
Validations

human liver tissue were subjected to SDS PAGE followed by western blot with Catalog No:114059(PON2 antibody) at dilution of 1:300

Immunofluorescent analysis of HepG2 cells, using PON2 antibody Catalog No:114059 at 1:50 dilution and Rhodamine-labeled goat anti-rabbit IgG (red). Blue pseudocolor = DAPI (fluorescent DNA dye).

IP Result of anti-PON2 (IP:Catalog No:114059, 4ug; Detection:Catalog No:114059 1:500) with L02 cells lysate 3200ug.

Immunohistochemistry of paraffin-embedded human liver cancer tissue slide using Catalog No:114059(PON2 Antibody) at dilution of 1:200 (under 10x lens)
Immunohistochemistry of paraffin-embedded human liver cancer tissue slide using Catalog No:114059(PON2 Antibody) at dilution of 1:200 (under 40x lens)

1X10^6 HepG2 cells were stained with 0.2ug PON2 antibody (Catalog No:114059, red) and control antibody (blue). Fixed with 90% MeOH blocked with 3% BSA (30 min). Alexa Fluor 488-congugated AffiniPure Goat Anti-Rabbit IgG(H+L) with dilution 1:1000.
-
Background
PON2(Serum paraoxonase/arylesterase 2) has antioxidant activity and can prevents LDL lipid peroxidation, reverses the oxidation of mildly oxidized LDL, and inhibits the ability of MM-LDL to induce monocyte chemotaxis. Highest levels of PON2 protein are found in the mouse lung and small intestine, followed by the heart and liver, while lower levels are present in the testis, kidney and brain. PON2 expression in tissues from female mice is always significantly higher than in male animals. There are also some reports showing two bands of 43 kDa and 53 kDa to be detected through western blot as the two isoforms of this protein. (PMID:21354197).
-
References
- Joe MK, Tomarev SI. Expression of myocilin mutants sensitizes cells to oxidative stress-induced apoptosis: implication for glaucoma pathogenesis. The American journal of pathology. 176(6):2880-90. 2010.
- Hagmann H, Kuczkowski A, Ruehl M. Breaking the chain at the membrane: paraoxonase 2 counteracts lipid peroxidation at the plasma membrane. FASEB journal : official publication of the Federation of American Societies for Experimental Biology. 28(4):1769-79. 2014.
Related Products / Services
Please note: All products are "FOR RESEARCH USE ONLY AND ARE NOT INTENDED FOR DIAGNOSTIC OR THERAPEUTIC USE"
